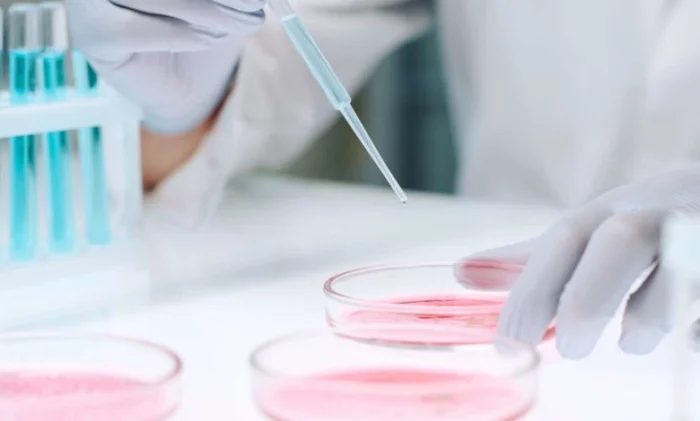

Многообещающее открытие для переработки пластика: эти микроорганизмы переваривают его при 15°C!
Определенные микроорганизмы могут разрушать пластик. Однако этот процесс трудно вывести на промышленный уровень. Потому что он происходит при слишком высокой температуре. Но исследователи только что обнаружили новые микробы, которые активны уже при 15 °C и могут помочь решить проблемы переработки отходов.
Решение проблемы загрязнения окружающей среды пластиком — одна из важнейших задач, стоящих перед нашим обществом. В течение некоторого времени исследователи надеялись найти решение в микроорганизмах, поедающих пластик. Проблема в том, что они обычно становятся активными только при температуре выше 30 °C. Это не только удорожает процесс, но и снижает его углеродную нейтральность.
Исследователи из Швейцарского федерального научно-исследовательского института WSL — от Wald, Schnee und Landschaft, что означает «лес, снег и ландшафт» — возможно, только что обнаружили новые таксоны микробов, которые могут помочь человечеству выбраться из трудного положения. Несколько штаммов бактерий и грибов, собранных из «пластисферы» Альп и Арктики.
Тесты, проведенные исследователями на этих микроорганизмах, показали, что 19 из них способны разрезать биоразлагаемый полиэстер-полиуретан (PUR) или коммерчески доступную биоразлагаемую смесь, поли(бутилен-адипат-терефталат) (PBAT) или полимолочную кислоту (PLA), на более мелкие молекулы. А два вида грибов могут даже переваривать все эти пластики. И все это при температуре не выше 15 °C.
Исследователи объясняют, что такая способность разлагать пластик, скорее всего, обусловлена сходством между растительным кутином и некоторыми полимерами пластика. Теперь осталось выяснить, какие ферменты, вырабатываемые штаммами микроорганизмов, действительно разлагают пластик. Это позволит оптимизировать процесс — а почему бы и не сделать его промышленным.